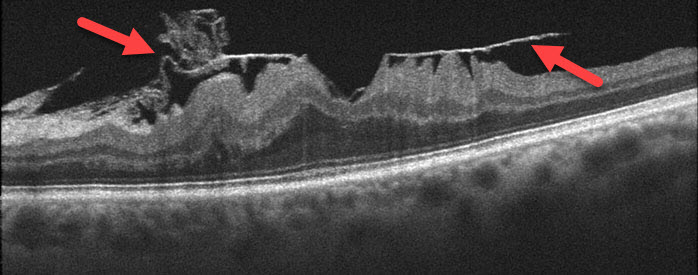

Some individuals will develop scar tissue that grows on the surface of the macula, the small, specialized area of the retina that gives us our straight-ahead reading and driving vision. If this scar tissue contracts, it causes the macula to wrinkle, or pucker. Although treatment is not recommended for those with minimal symptoms, surgery may be necessary with more severe central visual complaints. At Bennett & Bloom Eye Centers we take the time to carefully examine your eyes and recommend a course of treatment only if we are sure it is right for you.
Macular pucker (also referred to as preretinal fibrosis, epiretinal membrane, or cellophane maculopathy) consists of a cellophane-like membrane that grows over and mechanically “puckers” and distorts the macula.


Macular pucker usually occurs following separation of the vitreous from the surface of the retina (posterior vitreous detachment). Macular pucker can also occur following retinal tear or detachment, trauma, various eye inflammatory diseases, or as an isolated finding (idiopathic). It is not usually associated with medical conditions outside the eye.

The “puckered” macula causes the central vision to become blurred or distorted. Patients may be completely asymptomatic, especially when the other eye sees normally. Some may experience progressive vision loss, although the vision will stabilize for most patients within 6 months of the macular pucker developing.
You can’t diagnose macular pucker by looking in the mirror since your eye will usually look and feel normal. The diagnosis is made with a thorough retinal examination through a dilated pupil, OCT scanning, and fluorescein angiography.
Treatment for most patients with macular pucker is usually not necessary since many remain asymptomatic. Surgery should be considered, however, for those people whose distortion, vision loss, and difficulty with depth perception make their daily activities such as reading and driving difficult.
Vitrectomy surgery is performed in the operating room using local anesthesia. This advanced microsurgical technique allows us to restore vision by peeling and removing the pucker from the macular surface, allowing the underlying macula to smooth out and function more normally. Patients go home immediately following surgery. There is usually minimal to no pain, except for minor irritation from sutures which absorb within several weeks of surgery.


Patients usually notice decreased distortion within several weeks to months following vitrectomy. The level of visual acuity also usually improves by about 50% although it may take several years for maximal vision to return.
The major side-effect is a cataract, with many patients requiring cataract surgery within a year or two of vitrectomy. There is about a 1 in 20 chance of recurrent macular pucker, along with a very small chance of secondary retinal detachment or infection.